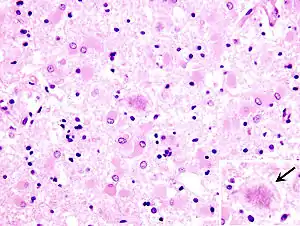

Хвороба Кройцфельда — Якоба
Хвороба Кро́йцфельда-Я́коба — захворювання людини з групи пріонових хвороб, що відносять до повільних інфекцій. Хворобу спричинює накопичення в людському організмі патогенних пріонів.
| Хвороба Кройцфельда—Якоба | |
|---|---|
![]() Гістопалогогічні зміни у померлого від хвороби Кройцфельда-Якоба локалізуються у лобній частині головного мозку. Відмічена стрілкою гліальна вакуоля, всередині якої помітна велика витіювата бляшка. Забарвлення гематоксилін-еозином, збільшення у 40 разів Гістопалогогічні зміни у померлого від хвороби Кройцфельда-Якоба локалізуються у лобній частині головного мозку. Відмічена стрілкою гліальна вакуоля, всередині якої помітна велика витіювата бляшка. Забарвлення гематоксилін-еозином, збільшення у 40 разів | |
| Спеціальність | неврологія |
| Симптоми | деменція[1] і myoclonusd[1] |
| Причини | пріон[1] |
| Метод діагностики | анамнез[1], неврологічні методи діагностикиd[1], МРТ[1], електроенцефалографія[1] і Аутопсія[1] |
| Ведення | невідомеd і паліативна допомога |
| Частота | 0.00015%, 0.024% |
| Класифікація та зовнішні ресурси | |
| МКХ-10 | A81.0, F02.1 |
| OMIM | 123400 |
| DiseasesDB | 3166 |
| MedlinePlus | 000788 |
| eMedicine | neuro/725 |
| MeSH | D007562 |
| | |
Історія захворювання
На початку 20-х років XX сторіччя німецький невролог Альфонс Якоб виявив п'ять випадків незвичайного ураження у людей віком від 30 до 50 років. Практично тоді ж німецький лікар Ганс-Ґергард Кройцфельд у своїй лікарні спостерігав подібну «неординарну» хворобу у 20-річної дівчини. На ранніх стадіях з'являлися порушення чутливості, біль у кінцівках, розлади вегетативної нервової системи. Пізніше наростали зміни зору аж до сліпоти, виникали неритмічні, швидкі, короткі скорочення окремих м'язів, які постійно поновлювалися. На цьому тлі помітні були ознаки наростаючого слабоумства із зубожінням спектра емоцій.
Перше повідомлення про підозру ятрогенної (медично обумовленої) хвороби Кройцфельда-Якоба з'явилося в 1974 році, коли експерименти на тваринах показали, що рогівка заражених тварин може передавати патогенні пріони, і вони поширюються по зорових шляхах. У 1977 році була зафіксована передача пріонів через заражені внутрішньомозкові електроди, які до цього були використані у людини з хворобою Кройцфельда-Якоба. Це відбулося незважаючи на попереднє знезараження електродів етанолом і формальдегідом. У 1985 році сталось передавання хвороби Кройцфельда-Якоба через гормони гіпофіза, взяті від трупа. Перше сповіщення про передачу хвороби Кройцфельда-Якоба через пересадку твердої мозкової оболони опубліковано у 1987 році, хоча, судячи з проаналізованої інформації, вперше це відбулось ще у 1969 році. У 1992 році було визнано, що людський гонадотропін, який вводять шляхом ін'єкції, може також передавати цю хворобу від людини до людини[2]. У 2004 році було заявлено про можливість передачі патологічних пріонів при переливанні крові[3].
Актуальність
Хвороба Кройцфельда-Якоба є найбільш поширеним пріоновим захворюванням людини, хоча є все-таки рідкісною, яка відбувається щороку приблизно у однієї людини на мільйон. Але на підставі обстеження 12 тис. чоловік було вирахувано, що частка перорального зараження людей новим варіантом хвороби Кройцфельда-Якоба від корів, хворих на коров'ячий сказ, дорівнює приблизно 237 випадкам на мільйон[4]. При цьому, на думку професора Джона Коллінджа[5], кількість інфікованих може бути в значній мірі недооціненою. Спорадична форма хвороби Кройцфельда-Якоба зустрічається з частотою близько 1 випадку на 1 млн осіб і сягає 85% всіх випадків цієї хвороби. Сімейна форма хвороби Кройцфельда-Якоба складає від 5 до 15% всіх випадків, ятрогенна форма — менше 5%[6].
Хвороба Кройцфельда-Якоба зазвичай уражає людей у віці 45-75 років, найбільш часто зустрічається у людей віком 60-65 років. Винятком з цього правила є новий варіант хвороби, який зустрічається в молодшому віці[7].
Етіологія
Детальніші відомості з цієї теми ви можете знайти в статті Пріони.
Детальніші відомості з цієї теми ви можете знайти в статті Пріонові хвороби.
Епідеміологія

У більшості пацієнтів патологічний пріон PrPsc з'являється спонтанно — шляхом мутації власного PrPc. В інших випадках можливе екзогенне зараження від тварин, які є основним джерелом збудника (вівці, кози, корови, олені та інші копитні тварини, норки, коти, можливо, й інші види). Відбувається й успадкування хвороби за автосомно-домінантним типом (щоправда, це непрямий процес — через попередню генну автореплікацію інфекційного агента), а також передаються аліментарним або ятрогенним (інтрацеребрально через пересадки рогівки, фрагментів твердої мозкової оболони, імплантацію внутрішньочерепних електродів, інтравенозно, інтраперитонеально, інтрадермально, при переливанні крові, застосуванні донорської сперми тощо) шляхами. Механізми передачі пріонів різноманітні і включають фекально-оральний, гіпотетично — гемоконтактний та аерозольний, можлива також вертикальна передача через плаценту. Передача пріонів можлива у разі споживання м'яса дорізаних хворих тварин частіше у період інкубації, коли у них будь-яких симптомів хвороби не спостерігається; а також під час розтину трупів. Враховуючи високу терморезистентність пріонів, звичайна термічна кулінарна обробка м'яса не знешкоджує збудника хвороби, тому заразитися можна й при споживанні вареного м'яса заражених тварин. Зараження може статись і при парентеральному введенні гормонів, виготовлених з органів інфікованих тварин (пітуїтрин) чи людей (гонадотропін). На небезпеку інфікування наражаються також працівники боєнь, м'ясокомбінатів під час забою тварин в інкубаційному періоді й контакту з їх тканинами та органами. Особливості епідемічного процесу серед споживачів м'яса інфікованих тварин вивчені недостатньо, а сам факт зараження людей від корів доведено лише на початку 90-х років XX століття, коли було виявлено новий варіант хвороби Кройцфельда-Якоба.
Детальніші відомості з цієї теми ви можете знайти в статті Пріонові хвороби.
Патогенез

Детальніші відомості з цієї теми ви можете знайти в статті Пріонові хвороби.
Клінічні прояви
Загальні риси
У МКХ-10 у класі «Деякі інфекційні та паразитарні хвороби», підкласі «Вірусні інфекції ЦНС» під кодом А81 включені «Атипові вірусні інфекції ЦНС», до яких включено «Хворобу Кройцфельда-Якоба» (А81.0)[8]. Хвороба Кройцфельда-Якоба триває від декількох тижнів до 8 років (у середньому 6 міс.). Виділяють клінічно:
- спорадичну,
- спадкову,
- ятрогенну,
- аміотрофічну форми хвороби Кройцфельда-Якоба,
- новий варіант хвороби Кройцфельда-Якоба.
Детальніші відомості з цієї теми ви можете знайти в статті Пріонові хвороби.
Спорадична форма
Початок спорадичної форми цієї хвороби часто непомітний. Іноді хворі скаржаться на загальне нездужання, головний біль, запаморочення, емоційну лабільність, невпевнену ходу. Надалі швидко прогресують інтелектуально-мнестичні розлади, передусім амнезія, зниження уваги і втрата фахових навичок. Спочатку вони критично оцінюються захворілими і бувають минущими. Проте невдовзі виявляються прогресуюче руйнування інтелекту, часом приєднуються неврологічні ознаки ураження мозочка і відділів мозку, які відають зоровою пам'яттю. Зрідка спостерігаються галюцинації або маревне мислення. Більш пізні прояви — яскрава дизартрія (мова нагадує «салат із слів»), швидко прогресуюча деменція і атаксія з міоклонією. Хворі втрачають здатність говорити та/або бачити. Недужі постійно перебувають у лежачому положенні, відмовляються від вживання їжі.
Сімейна форма
Найчастішими є мозочкові або зорові неврологічні прояви. Екстрапірамідна ригідність м'язів, міоклонія і грубі порушення на електроенцефалограмі виникають порівняно пізно. Протягом року від початку захворювання помирає близько 90% таких хворих.
Ятрогенна форма
Першою і найчастішою ознакою є деменція. Інкубаційний період зазвичай є 10-30 місяців. Якщо ж пріони потрапили в організм не безпосрередньо у мозок, а з периферії організму (наприклад, при введенні гормонів росту або гонадотропінів), то тоді інкубаційний період подовжується до 5 років і більше. Ці хворі страждають винятково на мозочкову атаксію.
«Новий варіант» хвороби Кройцфельда-Якоба
Вважається атиповим, тому що для нього властиве помітне переважання атаксії над деменцією.
Аміотрофічна форма
Є вкрай рідкісною. При ній також виявляються ознаки зниження функції мотонейронів з центральним паралічем і атрофією м'язів.
Гострий перебіг
Плинує швидко, розгорнуті симптоми наростають протягом 1 місяця. Їм не передують продромальні прояви, хвороба закінчується смертю через декілька місяців.
Підгострий перебіг
Характеризується наявністю продромальних ознак до початку захворювання з прогресуючою деменцією та атаксією.
Повільний тип перебігу
Йому притаманний тривалий період розвитку фокальних або дифузних неврологічних ознак.
Діагностика

Попередній діагноз хвороби Кройцфельда-Якоба можна встановити (при наявності характерних симптомів) за допомогою електроенцефалограми (ЕЕГ). На ЕЕГ в разі хвороби Кройцфельда-Якоба характерна поява трифазної активності, рання пароксизмальна активність зазвичай діагностується через 12 тижнів і більше від дебюту спорадичної форми. Фокальна, билатеральна і генералізована міоклонічна пароксизмальна активність діагностується на продромальній, початковій і термінальній стадіях хвороби Кройцфельда-Якоба відповідно. Можуть реєструватися різні види періодичної пароксизмальної активності: двофазні або трифазні періодичні комплекси, що виникають кожні 1-2 с; періодичні комплекси з мультіфазною конфігурацією; періодичні поліспайкові розряди. ЕЕГ-патерн («спалах-пригнічення») характерний для термінальної стадії захворювання з явищами глибокої атрофії кори.
Проводиться дослідження спинно-мозкової рідини на наявність білка 14-3-3 protein. Використовують й разом з тестом на білок 14-3-3 тест на визначення нейорон-специфічної енолази.
Для встановлення діагнозу хвороби Кройцфельда-Якоба потрібно виявити один з чотирьох додаткових критеріїв:
- наявність специфічних амілоїдних бляшок, які породжують пріони (Pr-амілоїдних бляшок);
- спроможність тканини до зараження спонгіоформною енцефалопатією тварин;
- наявність ізоформ пріон-протеїну Кройцфельда-Якоба;
- наявність патогенного мутованого гена PrNP.
Дуже чутливим методом вважають дослідження мигдаликів й лімфатичних вузлів, взятих шляхом біопсії у хворих[9]. На сьогодні завершуються дослідження, які мають дати змогу знаходити ізоформ пріон-протеїну Кройцфельда-Якоба за допомогою оптично-волоконного ІФА і певних специфічних антитіл до PrPsc, що має виявляти 1 частку на 1011 часток мозкової тканини[10]. У 2014 році було сповіщено, що можливо знайти PrPsc у носових ходах людини, що дає можливість ранньої діагностики хвороби Кройцфельда-Якоба[11].

У жовтні 2016 року британськими дослідниками було повідомлено, хворобу можна ідентифікувати за допомогою сечового тесту, який заснований на імуногістохімічному методі. На спеціальній смужці, яку занурюють в сечу хворого, за наявності в ній пріонів, спостерігають відповідну зміну забарвлення. Результати цього дослідження мають ще дослідити в інших діагностичних центрах, після чого цей тест буде подано для подальшої міжнародної сертифікації [12],[13].
Детальніші відомості з цієї теми ви можете знайти в статті Пріонові хвороби.
Лікування
Відомих та ефективних методів лікування хвороби на сьогодні не існує. Є припущення, що пентозана полісульфат здатний сповільнювати перебіг хвороби[14].
Детальніші відомості з цієї теми ви можете знайти в статті Пріонові хвороби.
Профілактика
Пріони не можуть бути інактивовані за допомогою звичайних стерілізаційних заходів обробки інструментів. Для цього слід застосовувати мідний купорос, гідроксид натрію або гіпохлорит натрію[15]. Перспективними вважають також такі заходи дезінфекції, які включають комбінацію миючих засобів та ферментів, подібну у біологічних пральних порошках.
Для запобігання захворювання на спорадичну форму і новий варіант хвороби Кройцфельда-Якоба слід обмежити вживання імпортної яловичини та м'ясних виробів (ковбаси, шинка, консерви тощо) із м'яса, яке може бути заражене. На державному рівні слід заборонити ввіз яловичини з країн, де зафіксовані випадки захворювання. Тварин, що визнані зараженими, та тих здорових. що входять в потенційно заражене стадо, утілізують шляхом спалювання.
Детальніші відомості з цієї теми ви можете знайти в статті Пріонові хвороби.
Примітки
- Bednařík J., Ambler Z., Růžička E. Klinická neurologie: část speciální — ISBN 978-80-7387-389-9
- Maura N. Ricketts, Neil R. Cashman, Elizabeth E. Stratton, and Susie ElSaadany Is Creutzfeldt-Jakob Disease Transmitted in Blood? Emerging Infectious Diseases Volume 3, Number 2—June 1997. р.155-163.
- Peden AH, Head MW, Ritchie DL, Bell JE, Ironside JW (2004). «Preclinical vCJD after blood transfusion in a PRNP codon 129 heterozygous patient». Lancet 364 (9433): 527-9. doi:10.1016/S0140-6736(04)16811-6. PMID 15302196
- Will RG, Ironside JW, Zeidler M, Cousens SN, Estibeiro K, Alperovitch A, Poser S, Pocchiari M, Hofman A, Smith PG. A new variant of Creutzfeldt-Jakob disease in the UK. Lancet. April 1996 — vol.347, issue№ 9006. — p. 921-5.
- Провідний британський експерт з хвороби Кройцфельда-Якоба.
- Variant Creutzfeldt-Jakob disease. Fact sheet N°180. Revised February 2012
- vCJD (Variant Creutzfeldt-Jakob Disease). Centers for Disease Control and Prevention. 2007-01-04. Архівовано 7 травня 2009 у Wayback Machine.
- Ця класифікація була впроваджена у 1993 році, тому й відображає застарілі поняття про пріонові хвороби, які не є вірусними. На 2015 рік планується впровадження МКХ 11-го перегляду, де ці класифікаційні моменти будуть виправлені.
- Florian P Thomas Variant Creutzfeldt-Jakob Disease and Bovine Spongiform Encephalopathy Workup. Histologic Findings. Medscape. Updated: Dec 3, 2013
- Rubenstein, R., et al. SOFIA: An Assay Platform for Ultrasensitive Detection of PrPSc in Brain and Blood. SUNY Downstate Medical Center. 2011-08-19.
- Orrú, C.D., Bongianni, M., Tonoli, G., Ferrari, S., Hughson, A.G., Groveman, B.R., Fiorini, M., Pocchiari, M., Monaco, S., Caughey, B., Zanusso, G. A test for Creutzfeldt-Jakob disease using nasal brushings. August 2014. New England Journal of Medicine. volume 371, issue 6, p. 530–9
- Urine test for CJD 'a possibility'(англ.)
- Urine test may detect Creutzfeldt-Jakob disease(англ.)
- Rainov NG, Tsuboi Y, Krolak-Salmon P, Vighetto A, Doh-Ura K Experimental treatments for human transmissible spongiform encephalopathies: is there a role for pentosan polysulfate? Expert opinion on biological therapy. 2007, volume 7, issue 5, pages 713–26.
- Solassol J, Pastore M, Crozet C (2006). «A novel copper-hydrogen peroxide formulation for prion decontamination». J Infect Dis 194 (6): 865–869. doi:10.1086/506947. PMID 16941355
Див. також
Джерела
- Stanley B. Prusiner Neurodegenerative Diseases and Prions. N Engl J Med 2001; 344:1516-1526.
- Herbert Budka Neuropathology of prion diseases. Br Med Bull (2003), 66 (1):121-130. doi: 10.1093/bmb/66.1.121
- Інфекційні хвороби (підручник) (за ред. О. А. Голубовської). — Київ: ВСВ «Медицина» (2 видання, доповнене і перероблене). — 2018. — 688 С. + 12 с. кольор. вкл. (О. А. Голубовська, М. А. Андрейчин, А. В. Шкурба та ін.) ISBN 978-617-505-675-2
- Max D. T. The Family That Couldn't Sleep: A Medical Mystery Paperback — Random House Trade Paperbacks.- 2007. — 336 стор.